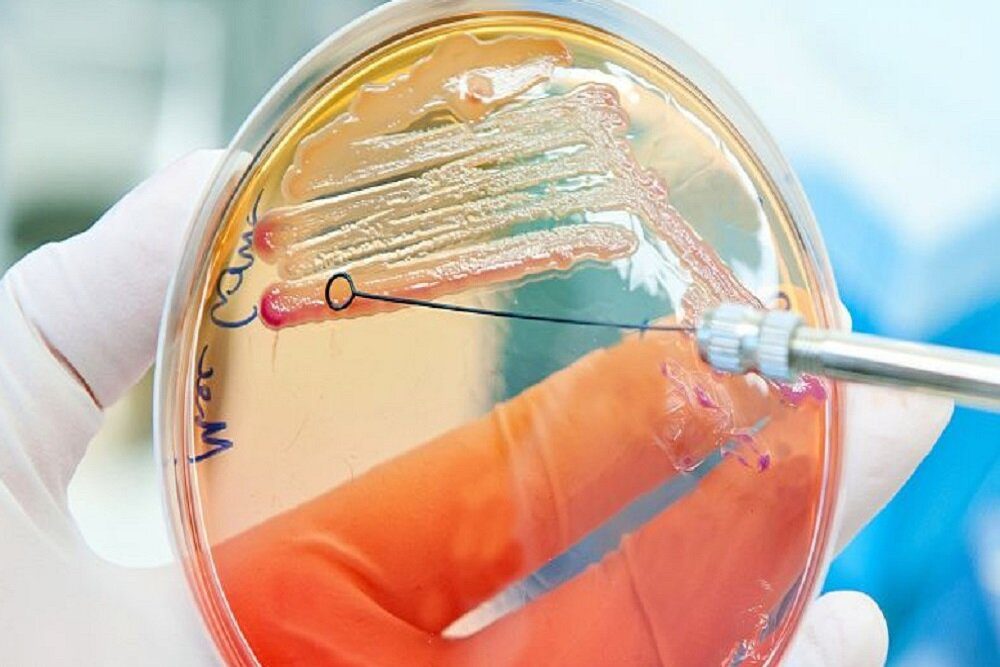

آنتیبیوتیک جدیدی که با باکتریهای خوب کاری ندارد
دانشمندان موفق به کشف یک آنتیبیوتیک انقلابی شدهاند که باکتریهای خوب را حفظ میکند و تنها باکتریهای بد را نابود میکند.
به گزارش مجله تیتر ۱۲ به نقل از ایسنا، با وجود تمام کارهایی که آنتیبیوتیک ها برای ما انجام داده و میدهند، یکی از بزرگترین معایب استفاده از آنها این است که آنها به طور بیرویه هم باکتریهای خوب و هم باکتریهای بد را از بین میبرند.
به نقل از اسای، مصرف یک دوره از این داروی نجاتبخش نه تنها میتواند مهاجمان بیماریزا را در بدن انسان نابود کند، بلکه همچنین میتواند تأثیر بسیاری بر روده و مجموعه میکروبهای ساکن آن داشته باشد.
این تاثیر گاهی اوقات میتواند منجر به رشد بیش از حد برخی باکتریها یا قارچها شود. به عنوان مثال، زنان پس از درمان آنتی بیوتیکی تا ۳۰ درصد احتمال ابتلا به عفونت قارچی را دارند.
دانشمندان دانشگاه ایلینوی در اوربانا شمپین(Urbana-Champaign) در حال کار بر روی یک راه حل هستند. آنها آنتی بیوتیک جدیدی به نام لولامیسین(lolamicin) کشف کردهاند که میتواند بر پاتوژنهای گِرَم منفی تأثیر بگذارد و در عین حال میکروبهای دیگر را به حال خود رها کند.
هنوز راه درازی تا آزمایش این دارو بر روی انسان در پیش است، اما محققان امیدوارند که بتواند به عنوان طرحی برای توسعه آنتی بیوتیکها در آینده باشد.
باکتریهای گرم منفی از علل شایع عفونت در رودهها، ریهها، مثانه و خون هستند و از بین بردن آنها بسیار دشوار است. مقاومت آنها در برابر آنتی بیوتیکهای کنونی یکی از فوریترین تهدیداتی است که سلامت جهانی بشر امروزی با آن مواجه است.
آنتی بیوتیکهای وسیع الطیف میتوانند هم باکتریهای گرم منفی و هم باکتریهای گرم مثبت را از بین ببرند، اما دانشمندان میگویند که نیاز اساسی برای یافتن دارویی وجود دارد که بتواند به طور خاص باکتریهای گرم منفی را مورد هدف قرار دهد، زیرا به احتمال زیاد در برابر آنتی بیوتیکهای فعلی ما مقاوم هستند. این کار به میکروبهای بیشتری که برای سلامتی انسان مفید هستند فرصت میدهد که در امان بمانند.
دارویی مانند لولامیسین میتواند یک بلیت به دنیایی جدید باشد. زمانی که لولامیسین در ظروف آزمایشگاهی در برابر ۱۳۰ سویه باکتریهای گرم منفی معمولی مقاوم به دارو مانند ای کولی(E. coli)، K. pneumoniae و E. cloacae قرار گرفت، این دارو تک تک آنها را از بین برد و موفق به کاری شد که بسیاری از آنتی بیوتیکهای دیگر در آن شکست خوردند.
در جوندگان نیز لولامیسین با موفقیت پنومونی حاد و عفونتهای خونی را درمان کرد و در عین حال میکروبیوم روده آنها را حفظ کرد.
در واقع دانشمندان دریافتند که این دارو هیچ تاثیری بر باکتریهای گرم مثبت یا باکتریهای گرم منفی غیر بیماریزا که در موشها زندگی میکردند، نداشته است.
با توجه به اینکه حتی یک دوره کوتاه از مصرف آنتی بیوتیک نیز میتواند باعث کاهش سریع تنوع گونههای میکروبی ساکن در روده انسان شود، این یک کشف هیجان انگیز است.
پیامدهای سلامتی این تغییرات به خوبی درک نشده است، اما به نظر میرسد که پس از استفاده از آنتی بیوتیکهای خاص، بیمار را در معرض عفونتهای ثانویه قرار میدهد.
لولامیسین متفاوت است. برخلاف آنتی بیوتیک رایج آموکسیسیلین یا کلیندامایسین(آنتی بیوتیکی که فقط باکتریهای گرم مثبت را از بین میبرد)، این داروی جدید منجر به تغییرات اساسی در میکروبیوم روده موشها در یک ماه یا بیشتر پس از درمان نمیشود.
در طول این مدت، موشهایی که تحت درمان با لولامیسین قرار گرفته بودند، در معرض عفونت باکتریایی قرار گرفتند که اغلب به دنبال مصرف آنتی بیوتیک در روده بزرگ ایجاد میشود. موشهایی که تحت درمان با لولامایسین قرار گرفتند، تقریباً به همان میزانی که با کلیندامایسین یا آموکسیسیلین درمان شدند، به عفونت C. difficile مبتلا نشدند.
با توجه به اینکه ایالات متحده به تنهایی هر ساله تقریباً ۵۰۰ هزار عفونت C. difficile را تجربه میکند که ۳۰ هزار مورد آن کشنده است، توسعه یک آنتی بیوتیک محافظ میکروبیوم میتواند نجات دهنده باشد.
دانشمندان اکنون در تلاش هستند تا کار خود را بهینه کنند تا اطمینان حاصل شود که پاتوژنها در طول زمان به لولامیسین مقاوم نمیشوند.
پژوهشگران میگویند: میکروبیوم روده برای حفظ سلامت میزبان نقش اساسی دارد و اختلال در آن میتواند منجر به بسیاری از اثرات مضر از جمله عفونت C. difficile و فراتر از آن شود. در نتیجه، آنتی بیوتیکهای خاص پاتوژن مانند لولامیسین برای به حداقل رساندن آسیب جانبی به میکروبیوم روده حیاتی خواهد بود. این اثر حفظ میکروبیوم باعث برتری چنین آنتی بیوتیکهایی برای بیماران در مقایسه با آنتی بیوتیکها در عملکرد بالینی فعلی میشود.
این مطالعه در مجله نیچر(Nature) منتشر شده است.
پایان


